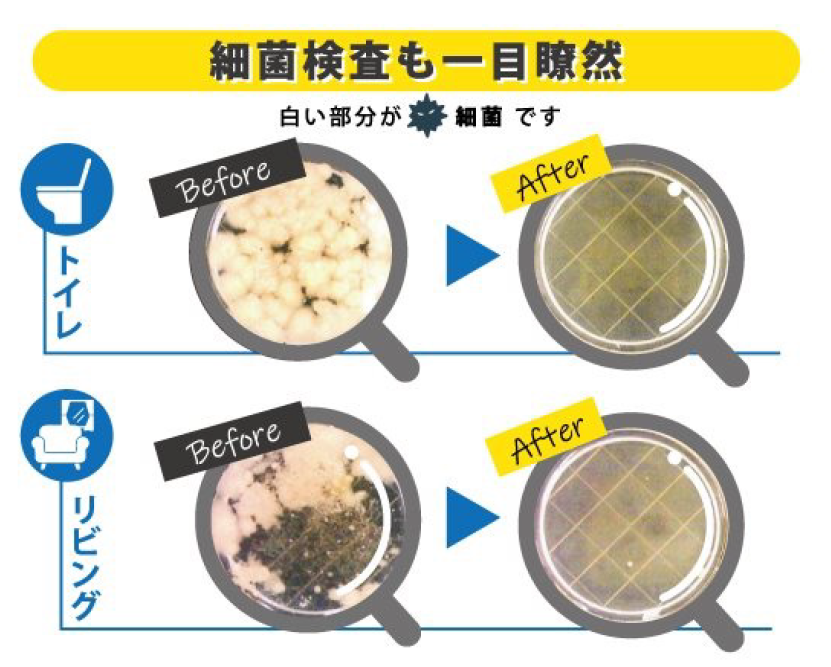

光触媒とは・・・!?
光触媒の主原料は、日焼け止めやスキンケア商品にも使われる安全な物質、酸化チタンです。
塗布した床・壁・天井・家具等に、太陽光や蛍光灯の光が当たると、強力な分解作用が生じ、有機物や有害物質を酸化分解します。
このメカニズムを利用した、クリーンな環境浄化力が光触媒です。
5,000分の1ミリの超粒子が床・壁・天井・家具等の細かい凹凸や、カーテンや絨毯等の繊維の奥まで入り込みます。
無色無臭でガラス製品等、どんな物でも施行でき、長い間、効果が持続します!

細菌検査で抗菌効果実証済み
一度の塗布施工で効果は3~5年。専用機械で施行するから効果長持ち!

新築時に施工すれば効果が倍増します
光触媒は何に効果があるのか?
抗菌・除菌
インフルエンザウイルス、ノロウイルス、黄色ブドウ球菌等、あらゆる細菌・悪玉菌の撃退、除菌ができます。その効果は、ほぼ100%。病院でも用いられるほど除菌力が強く、あらゆるウイルス、細菌・悪玉菌を撃退します。(※すべての菌を分解できるわけではありません。)
防汚
窓ガラス、外壁、手垢やタバコのヤニ、台所の油汚れ等を分解し、長期間汚れを防ぎます。鏡やガラス、プラスチックやそして陶器や布に至るまで、細かい凹凸や繊維の隙間に付着します。また、特殊なノリを配合しているため、水で流すような場所でもいっしょに流れてしまうことはなく、カビの元となる菌を分解してカビの発生を防ぎます
アレルギー
壁やガラスに花粉を付きにくくし、ハウスダストの元になるダニの死骸や花粉なども分解、抑制して、アレルゲンの無害化、アトピーや花粉症に悩まされる人たちを守ります。
消臭
タバコの臭いやペット臭、トイレのアンモニア臭等、いわゆる「生活臭」を全て分解し、快適な空間を作ります。
施行の流れ
光触媒施工の作業風景
